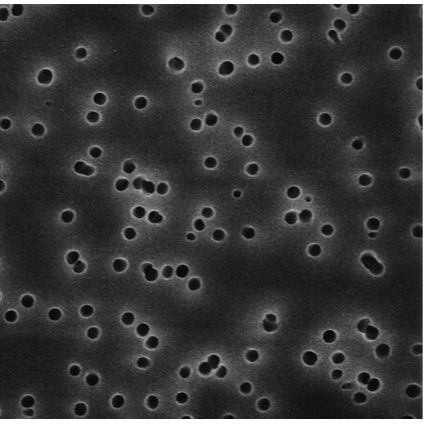
产品封面图

相关产品推荐更多 >
万千商家帮你免费找货
0 人在求购买到急需产品
- 详细信息
- 询价记录
- 文献和实验
- 技术资料
- 库存:
Isopore 表面滤膜,聚碳酸酯,亲水,0.1 µm,25 mm
- 保修期:
VCTP02500
- 规格:
100片/盒
VCTP02500 MilliporeIsopore 表面滤膜,聚碳酸酯,亲水,0.1 µm,25 mm,白色,光面
| 描述 | |
|---|---|
| 产品目录编号 | VCTP02500 |
| 商名 |
|
| 描述 | Isopore 表面滤膜,聚碳酸酯,亲水,0.1 µm,25 mm,白色,光面 |
| 背景信息 | The Isopore™ membrane is a polycarbonate, track-etched screen filter recommended for all analyses in which the sample is viewed on the surface of the membrane. Isopore™ membrane offers distinct advantages for the analysis of airborne contaminants and other particles using optical or electron microscopy. The Isopore™ membrane is composed of polycarbonate film, which has a smooth, glass-like surface for clearer sample observation. The unique manufacturing process of the membrane ensures a precise pore diameter and a consistent pore size for accurate separation of samples by size. Matched-weight filters are not usually required because of low, constant tar and ash weights. Features & Benefits: •Membrane structure retains particles on the surface, simplifying counting and analysis •Isopore™ membranes do not stain, resulting in low background interference •Non-hygroscopic, allowing for rapid drying and reduced sample analysis time •Translucent material does not require clearing for transmitted light microscopy; also available in brown variety Applications: Air Monitoring, Epifluorescent Microscopy, Chemotaxis Assays |
| 产品信息 | |
|---|---|
| 过滤器代码 | VCTP |
| 过滤器颜色 | 白色 |
| 最高工作温度 | 140 °C (possible reduction in flow rates may occur after autoclaving) |
| 过滤器类型 | 表面滤膜 |
| 应用 | |
|---|---|
| 应用 | 0.1 µm pore size, hydrophilic polycarbonate membrane, 25 mm diameter |
| Contaminant of Interest |
|
| Regulated Test Method Number |
|
| 生物信息 | |
|---|---|
| 媒质 | Isopore® |
| 可湿润性 | 亲水性 |
| 理化信息 | |
|---|---|
| 折射系数 | 1.6 |
| 孔径 | 0.1 µm |
| 空气流量 | 0.000367 L/min x cm²/psi |
| 23°C时的泡点 | ≥5.5 bar, air with water |
| 重量分析的提取物(%) | < 1% |
| 孔隙率% | 4.18% |
| 水流量 |
|
| 尺寸 | |
|---|---|
| 过滤器表面 | 平纹 |
| 厚度 | 25 µm |
| 过滤器直径 (⌀) | 25 mm |
| 材料信息 | |
|---|---|
| 化学 |
|
| 包装信息 | |
|---|---|
| 数量 | 100 |
风险提示:丁香通仅作为第三方平台,为商家信息发布提供平台空间。用户咨询产品时请注意保护个人信息及财产安全,合理判断,谨慎选购商品,商家和用户对交易行为负责。对于医疗器械类产品,请先查证核实企业经营资质和医疗器械产品注册证情况。
- 作者
- 内容
- 询问日期
 文献和实验
文献和实验利用CORTECS 2.7 µm色谱柱进行奥美拉唑的强制降解分析
简介 对于药物化合物生产而言,化学稳定性试验至关重要。口服制剂尤为如此。胃肠道消化会改变活性药物成分(API),产生具有潜在危害性的副产物。因此在开发过程中,能否对这些副产物进行检测和定性无疑非常重要。要对一种化合物进行定性,必须将所有降解产物与主要化合物分离开来。CORTECS2.7µm色谱柱为复杂样品的分析提供了优异的峰形与分离度。这款色谱柱填充了2.7µm的实心颗粒填料,能获得比全多孔色谱柱更高的分离度以及更低的背压。一般来说,由于150 mm亚3 µm色谱柱会在HPLC系统上产生高反
Protocol for isolating DNA from embryo yolk sacs, or toes, or 2 mm tail for PCR
(not Tris base). The pH is about 5. Don't adjust the pH. For yolk sac/placenta/tail/toes 2. Add 40 µl (100 µl for tail/toe) 25 mM NaOH / 0.2 mM EDTA. 3. Place at 95°C for 20 minutes (in a thermal cycler) 4. Add 40 µl (100 µl for tail/toe) 40 mM Tris
DNeasy 96植物技术:使用搅拌磨MM 300从新鲜植物叶片中分离DNA
in each well of the DNeasy 96 Plate. If lysate remains in any of the wells, centrifuge for a further 4 min(AirPore Tape可避免在离心过程中样品之间交叉污染。离心完后,检查所有的裂解溶液量否通过DNeasy 96 Plate每个孔底部的滤膜。如果任何孔中仍有残留,再离心4 min)。.16 、Remove the tape. Carefully add 800 µl Buffer AW to each sample (除去
 技术资料
技术资料暂无技术资料 索取技术资料